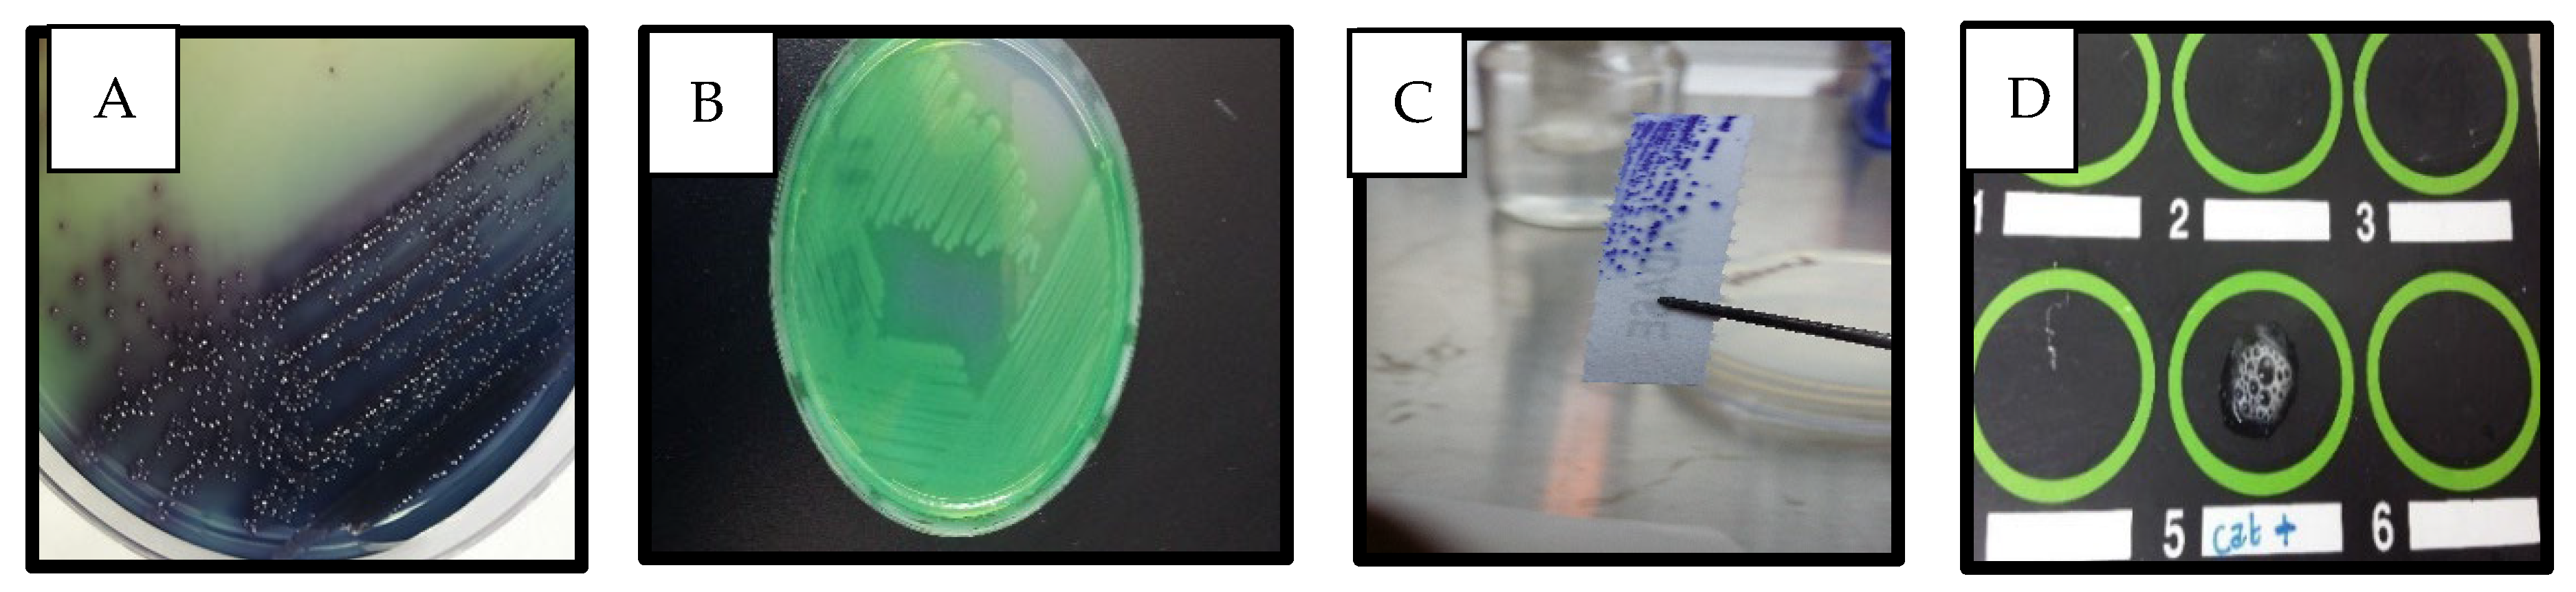
Antibiotics 14 00509 g001

Accurate Diagnosis of Pseudomonas aeruginosa Is Critical to Mitigating Development of Antibiotic Resistance
Abstract
1. Introduction
2. Results
Detection of P. aeruginosa in Clinical Samples
3. Discussion
4. Materials and Methods
4.1. Sample Collection
4.1.1. Biochemical Characterization
4.1.2. Extraction of Pyocyanin
4.1.3. Molecular Identification by Polymerase Chain Reaction (PCR)
4.2. Microliter Plate Assay
| Strongly adherent 4ODc < OD |
| Moderately adherent 2ODc < OD ≤ 4ODc |
| Weakly adherent ODc < OD ≤ 2 ODc |
| Non-adherent ODi ≤ ODc |
4.3. Statistical Analysis
5. Conclusions
Author Contributions
Funding
Institutional Review Board Statement
Informed Consent Statement
Data Availability Statement
Acknowledgments
Conflicts of Interest
References
- Healthcare Business News, Trends & Developments Healthcare-in-Europe.com. Available online: https://healthcare-in-europe.com/en/home/ (accessed on 1 February 2025).
- Ito, C.A.S.; Bail, L.; Arend, L.N.V.S.; da Nogueira, K.S.; Tuon, F.F. The Activity of Ceftazidime/Avibactam against Carbapenem-Resistant Pseudomonas aeruginosa. Infect. Dis. 2021, 53, 386–389. [Google Scholar] [CrossRef] [PubMed]
- Litwin, A.; Rojek, S.; Gozdzik, W.; Duszynska, W. Pseudomonas aeruginosa Device Associated—Healthcare Associated Infections and Its Multidrug Resistance at Intensive Care Unit of University Hospital: Polish, 8.5-Year, Prospective, Single-Centre Study. BMC Infect. Dis. 2021, 21, 180. [Google Scholar] [CrossRef]
- O’Donnell, J.N.; Bidell, M.R.; Lodise, T.P. Approach to the Treatment of Patients with Serious Multidrug-Resistant Pseudomonas aeruginosa Infections. Pharmacother. J. Hum. Pharmacol. Drug Ther. 2020, 40, 952–969. [Google Scholar] [CrossRef]
- Rezzoagli, C.; Archetti, M.; Mignot, I.; Baumgartner, M.; Kümmerli, R. Combining Antibiotics with Antivirulence Compounds Can Have Synergistic Effects and Reverse Selection for Antibiotic Resistance in Pseudomonas aeruginosa. PLoS Biol. 2020, 18, e3000805. [Google Scholar] [CrossRef]
- Tuon, F.F.; Dantas, L.R.; Suss, P.H.; Tasca Ribeiro, V.S. Pathogenesis of the Pseudomonas aeruginosa Biofilm: A Review. Pathogens 2022, 11, 300. [Google Scholar] [CrossRef] [PubMed]
- Breidenstein, E.B.M.; de la Fuente-Núñez, C.; Hancock, R.E.W. Pseudomonas aeruginosa: All Roads Lead to Resistance. Trends Microbiol. 2011, 19, 419–426. [Google Scholar] [CrossRef]
- IHME Pathogen Core Group. Global Burden Associated with 85 Pathogens in 2019: A Systematic Analysis for the Global Burden of Disease Study 2019. Lancet. Infect. Dis. 2024, 24, 868–895. [Google Scholar] [CrossRef] [PubMed]
- World Health Organization. WHO Bacterial Priority Pathogens List, 2024: Bacterial Pathogens of Public Health Importance to Guide Research, Development and Strategies to Prevent and Control Antimicrobial Resistance. Available online: https://www.who.int/publications/i/item/9789240093461 (accessed on 1 February 2025).
- Gellatly, S.L.; Hancock, R.E.W. Pseudomonas aeruginosa: New Insights into Pathogenesis and Host Defenses. Pathog. Dis. 2013, 67, 159–173. [Google Scholar] [CrossRef]
- O’Neill, J. Antimicrobial Resistance: Tackling a Crisis for the Health and Wealth of Nations. Review on Antimicrobial Resistance. 2014. Available online: https://amr-review.org/sites/default/files/AMR%20Review%20Paper%20-%20Tackling%20a%20crisis%20for%20the%20health%20and%20wealth%20of%20nations_1.pdf (accessed on 15 January 2025).
- CDC. About Pseudomonas aeruginosa. Pseudomonas aeruginosa. Available online: https://www.cdc.gov/pseudomonas-aeruginosa/about/index.html (accessed on 15 January 2025).
- CDC. COVID-19: U.S. Impact on Antimicrobial Resistance, Special Report 2022. Atlanta, GA: U.S. Department of Health and Human Services. Available online: https://www.thelancet.com/journals/lancet/article/PIIS0140-6736%2821%2902724-0/fulltext (accessed on 15 January 2025).
- CDC. Antibiotic Resistance Threats in the United States; U.S. Department of Health and Human Services: Atlanta, GA, USA, 2019. Available online: https://www.cdc.gov/antimicrobial-resistance/data-research/threats/index.html (accessed on 15 January 2025).
- Jordan Ministry of Health, 2023, Jordan Surveillance of Antimicrobial Resistance Annual Report 2022. Available online: https://www.moh.gov.jo/ebv4.0/root_storage/ar/eb_list_page/jordan_national_amr_surveillance_report_2023.pdf (accessed on 1 February 2025).
- Al-Orphaly, M.; Hadi, H.A.; Eltayeb, F.K.; AlHail, H.; Samuel, B.G.; Sultan, A.A.; Skariah, S. Epidemiology of multidrug-resistant Pseudomonas aeruginosa in the Middle East and North Africa region. mSphere 2021, 6, e00202-21. [Google Scholar] [CrossRef]
- Abu-Niaaj, L.F.; Al-Daghistani, H.I.; Katampe, I.; Abu-Irmaileh, B.; Bustanji, Y.K. Pomegranate Peel: Bioactivities as Antimicrobial and Cytotoxic Agents. Food Sci. Nutr. 2024, 12, 2818–2832. [Google Scholar] [CrossRef]
- Al-Daghistani, H.I.; Abu-Niaaj, L.F.; Bustanji, Y.; Al-Hamaideh, K.D.; Al-Salamat, H.; Nassar, M.N.; Jaber, H.M.; Amer, N.H.; Abu-Irmaileh, B.; Al-Nuaimi, A.H.D. Antibacterial and Cytotoxicity Evaluation of Arum Hygrophilum Bioss. Dir. Open Access J. 2021, 25, 7306–7316. [Google Scholar] [CrossRef]
- Qaralleh, H.; Saghir, S.A.M.; Al-limoun, M.O.; Dmor, S.M.; Khleifat, K.; Al-Ahmad, B.E.M.; Al-Omari, L.; Tabana, Y.; Mothana, R.A.; Al-Yousef, H.M.; et al. Effect of Matricaria aurea Essential Oils on Biofilm Development, Virulence Factors and Quorum Sensing-Dependent Genes of Pseudomonas aeruginosa. Pharmaceuticals 2024, 17, 386. [Google Scholar] [CrossRef] [PubMed]
- Khleifat, K.; Qaralleh, H.; Al-Limoun, M.; Alqaraleh, M.; Abu Hajleh, M.N.; Al-Frouhk, R.; Al-Omari, L.; Buqain, R.A.; Dmour, S.M. Antibacterial Activity of Silver Nanoparticles Synthesized by Aspergillus flavus and its Synergistic Effect with Antibiotics. J. Pure Appl. Microbiol. 2022, 16, 1722–1735. [Google Scholar] [CrossRef]
- Al-Akhras, A.A.; Zahra, J.A.; El-Abadelah, M.M.; Abu-Niaaj, L.F.; Khanfar, M.A. 8-Amino-7-(Aryl/Hetaryl) Fluoroquinolones. An Emerging Set of Synthetic Antibacterial Agents. Z. Naturforschung C 2022, 78, 157–168. [Google Scholar] [CrossRef] [PubMed]
- Bristy, S.F.; Uddin, M.R.; Meghla, B.A.; Tisha, T.A.; Uddin, M.A.; Islam, M.T.; Mie, M.; Kobatake, E.; Khondoker, M.U.; Mou, T.J.; et al. Misdiagnosis of bacterial pathogens by the diagnostic centers: A potential route for antibiotic resistance. J. Appl. Pharm. Sci. 2024, 14, 163–173. [Google Scholar] [CrossRef]
- Jami Al-Ahmadi, G.; Zahmatkesh Roodsari, R. Fast and Specific Detection of Pseudomonas aeruginosa from Other Pseudomonas Species by PCR. Ann. Burn. Fire Disasters 2016, 29, 264–267. [Google Scholar]
- Hemmati, J.; Nazari, M.; Fatemeh Sadat Abolhasani; Ahmadi, A.; Asghari, B. In Vitro Investigation of Relationship between Quorum-Sensing System Genes, Biofilm Forming Ability, and Drug Resistance in Clinical Isolates of Pseudomonas aeruginosa. BMC Microbiol. 2024, 24, 99. [Google Scholar] [CrossRef]
- Elexson, N.; Sabrina, H.; Dalene, L.; Eddy, B.; Nurul, F.R.; Nasra, P.; Grace, B.; Nick, L.; Amirah, Z.J.; Nur, D.Z.; et al. Assessment of Pseudomonas aeruginosa biofilm-forming capacities from drinking water in water vending machine. Food Res. 2022, 6, 76–83. [Google Scholar]
- Shouman, H.; Heba Shehta Said; Kenawy, H.I.; Hassan, R. Molecular and Biological Characterization of Pyocyanin from Clinical and Environmental Pseudomonas aeruginosa. Microb. Cell Factories 2023, 22, 166. [Google Scholar] [CrossRef]
- Rani, A.; Azmi, W. An overview on biosynthesis and applications of extracellular pyocyanin pigment and its role in Pseudomonas aeruginosa pathogenesis. Ann. Phytomed. 2019, 10, 90. [Google Scholar] [CrossRef]
- Bhargava, N.; Sharma, P.; Capalash, N. Pyocyanin Stimulates Quorum Sensing-Mediated Tolerance to Oxidative Stress and Increases Persister Cell Populations in Acinetobacter Baumannii. Infect. Immun. 2014, 82, 3417–3425. [Google Scholar] [CrossRef]
- Mudaliar, S.B.; Bharath Prasad, A.S. A Biomedical Perspective of Pyocyanin from Pseudomonas aeruginosa: Its Applications and Challenges. World J. Microbiol. Biotechnol. 2024, 40, 90. [Google Scholar] [CrossRef] [PubMed]
- Jayaseelan, S.; Ramaswamy, D.; Dharmaraj, S. Pyocyanin: Production, Applications, Challenges and New Insights. World J. Microbiol. Biotechnol. 2014, 30, 1159–1168. [Google Scholar] [CrossRef]
- Meirelles, L.A.; Newman, D.K. Both Toxic and Beneficial Effects of Pyocyanin Contribute to the Lifecycle of Pseudomonas aeruginosa. Mol. Microbiol. 2018, 110, 995–1010. [Google Scholar] [CrossRef] [PubMed]
- O’Malley, Y.; Reszka, K.J.; Rasmussen, G.T.; Abdalla, M.Y.; Denning, G.M.; Britigan, B.E. The Pseudomonas Secretory Product Pyocyanin Inhibits Catalase Activity in Human Lung Epithelial Cells. Am. J. Physiol.-Lung Cell. Mol. Physiol. 2003, 285, L1077–L1086. [Google Scholar] [CrossRef] [PubMed]
- Hall, S.; McDermott, C.; Anoopkumar-Dukie, S.; McFarland, A.; Forbes, A.; Perkins, A.; Davey, A.; Chess-Williams, R.; Kiefel, M.; Arora, D.; et al. Cellular Effects of Pyocyanin, a Secreted Virulence Factor of Pseudomonas aeruginosa. Toxins 2016, 8, 236. [Google Scholar] [CrossRef]
- Foksiński, P.; Blank, A.; Kaczorek-Łukowska, E.; Małaczewska, J.; Wróbel, M.; Wójcik, E.A.; Sowińska, P.; Pietrzyk, N.; Matusiak, R.; Wójcik, R. Does Every Strain of Pseudomonas aeruginosa Attack the Same? Results of a Study of the Prevalence of Virulence Factors of Strains Obtained from Different Animal Species in Northeastern Poland. Pathogens 2024, 13, 979. [Google Scholar] [CrossRef]
- Chimi, L.Y.; Noubom, M.; Bisso, B.N.; Singor Njateng, G.S.; Dzoyem, J.P. Biofilm Formation, Pyocyanin Production, and Antibiotic Resistance Profile of Pseudomonas aeruginosa Isolates from Wounds. Int. J. Microbiol. 2024, 2024, 1207536. [Google Scholar] [CrossRef] [PubMed] [PubMed Central]
- Thi, M.T.T.; Wibowo, D.; Rehm, B.H.A. Pseudomonas aeruginosa Biofilms. Int. J. Mol. Sci. 2020, 21, 8671. [Google Scholar] [CrossRef]
- Pritt, B.; O’Brien, L.; Winn, W. Mucoid Pseudomonasin Cystic Fibrosis. Am. J. Clin. Pathol. 2007, 128, 32–34. [Google Scholar] [CrossRef]
- Donlan, R.M.; Costerton, J.W. Biofilms: Survival Mechanisms of Clinically Relevant Microorganisms. Clin. Microbiol. Rev. 2002, 15, 167–193. [Google Scholar] [CrossRef] [PubMed]
- Høiby, N.; Ciofu, O.; Bjarnsholt, T. Pseudomonas aeruginosa biofilms in Cystic Fibrosis. Future Microbiol. 2010, 5, 1663–1674. [Google Scholar] [CrossRef] [PubMed]
- Schulze, A.; Mitterer, F.; Pombo, J.P.; Schild, S. Biofilms by Bacterial Human Pathogens: Clinical Relevance—Development, Composition and Regulation—Therapeutical Strategies. Microb. Cell 2021, 8, 28–56. [Google Scholar] [CrossRef]
- Shaw, E.; Wuest, W.M. Virulence Attenuating Combination Therapy: A Potential Multi-Target Synergy Approach to Treat Pseudomonas aeruginosa Infections in Cystic Fibrosis Patients. RSC Med. Chem. 2020, 11, 358–369. [Google Scholar] [CrossRef] [PubMed]
- Wu, M.; Li, X. Klebsiella Pneumoniae and Pseudomonas aeruginosa. Mol. Med. Microbiol. 2015, 3, 1547–1564. [Google Scholar] [CrossRef]
- Alexander, S.K.; Strete, D. Microbiology; A Photographic Atlas for the Laboratory, Benjamin Cummings; Addison Wesley Longman, Inc.: Mishawaka, IN, USA, 2001; pp. 102–104. [Google Scholar]
- Acharya, T. Nitrate Reduction Test: Principle, Procedure and Results. Available online: http://microbeonline.com/nitrate-reduction-test-principle-procedure-results/ (accessed on 15 January 2025).
- Darwesh, O.M.; Barakat, K.M.; Mattar, M.Z.; Sabae, S.Z.; Hassan, S.H. Production of Antimicrobial Blue Green Pigment Pyocyanin by Marine Pseudomonas aeruginosa. Biointerface Res. Appl. Chem. 2019, 9, 4334–4339. [Google Scholar] [CrossRef]
- El-Fouly, M.; Shahin, A.; El-Bialy, H.A.; Omara, A. Biosynthesis of pyocyanin pigment by Pseudomonas aeruginosa. J. Radiat. Res. Appl. Sci. 2014, 8, 36–48. [Google Scholar] [CrossRef]
- Kırmusaoğlu, S.; Kaşıkçı, H. Identification of ica-dependent biofilm production by Staphylococcus aureus clinical isolates and antibiofilm effects of ascorbic acid against biofilm production. J. Clin. Pathol. 2020, 73, 261–266. [Google Scholar] [CrossRef]
- Adeyemo, R.O.; Famuyide, I.M.; Dzoyem, J.P.; Lyndy Joy, M. Anti-Biofilm, Antibacterial, and Anti-Quorum Sensing Activities of Selected South African Plants Traditionally Used to Treat Diarrhoea. Evid.-Based Complement. Altern. Med. 2022, 2022, e1307801. [Google Scholar] [CrossRef]

| Isolate Producing Pyocyanin | Source of Isolate | Absorption at 520 nm | Conc. Pyocyanin (μg/mL) |
|---|---|---|---|
| 1 | Sputum | 2.135 | 36.448 |
| 2 | Ear | 0.802 | 13.692 |
| 3 | Wound | 0.200 | 3.414 |
| 4 | Wound | 0.010 | 0.171 |
| 5 | Urine | 0.013 | 0.222 |
| 6 | Urine | 0.017 | 0.290 |
| 7 | Skin | 0.120 | 2.048 |
| 8 | Skin | 0.100 | 1.707 |
| 9 | Skin | 0.094 | 1.605 |
Disclaimer/Publisher’s Note: The statements, opinions and data contained in all publications are solely those of the individual author(s) and contributor(s) and not of MDPI and/or the editor(s). MDPI and/or the editor(s) disclaim responsibility for any injury to people or property resulting from any ideas, methods, instructions or products referred to in the content. |
© 2025 by the authors. Licensee MDPI, Basel, Switzerland. This article is an open access article distributed under the terms and conditions of the Creative Commons Attribution (CC BY) license (https://creativecommons.org/licenses/by/4.0/).
Share and Cite
Al-Daghistani, H.I.; Abu-Niaaj, L.F.; Zein, S. Accurate Diagnosis of Pseudomonas aeruginosa Is Critical to Mitigating Development of Antibiotic Resistance. Antibiotics 2025, 14, 509. https://doi.org/10.3390/antibiotics14050509
Al-Daghistani HI, Abu-Niaaj LF, Zein S. Accurate Diagnosis of Pseudomonas aeruginosa Is Critical to Mitigating Development of Antibiotic Resistance. Antibiotics. 2025; 14(5):509. https://doi.org/10.3390/antibiotics14050509
Chicago/Turabian StyleAl-Daghistani, Hala I., Lubna F. Abu-Niaaj, and Sima Zein. 2025. "Accurate Diagnosis of Pseudomonas aeruginosa Is Critical to Mitigating Development of Antibiotic Resistance" Antibiotics 14, no. 5: 509. https://doi.org/10.3390/antibiotics14050509
APA StyleAl-Daghistani, H. I., Abu-Niaaj, L. F., & Zein, S. (2025). Accurate Diagnosis of Pseudomonas aeruginosa Is Critical to Mitigating Development of Antibiotic Resistance. Antibiotics, 14(5), 509. https://doi.org/10.3390/antibiotics14050509

